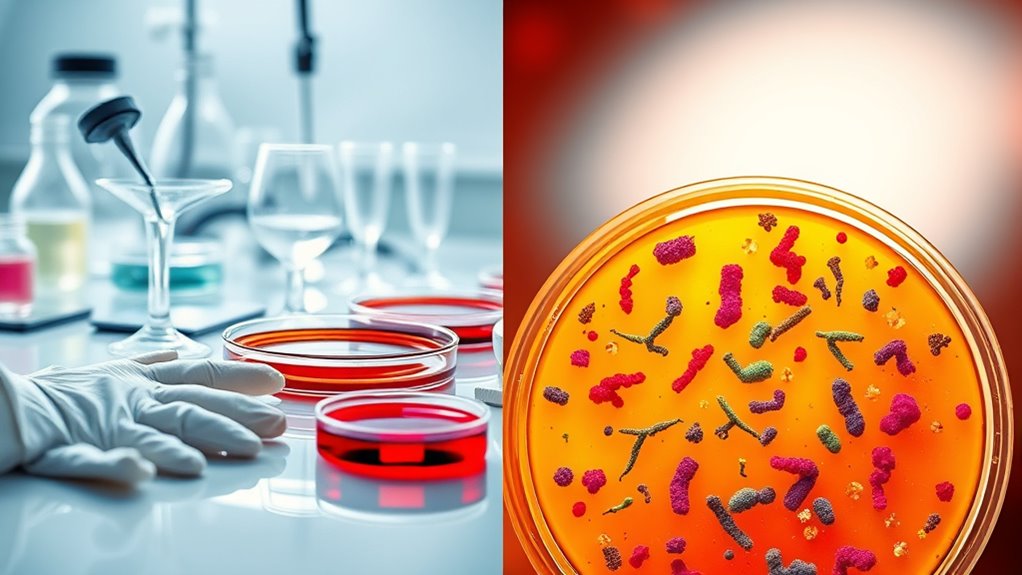

When choosing between sterile and living hydroponic systems, consider your goals for control, disease prevention, and sustainability. Sterile setups give you tight control over nutrients and help prevent diseases by eliminating microbes, but they may require more chemical inputs. Living systems promote natural resilience and microbial diversity, which can reduce inputs and support eco-friendly growth. To make an informed decision aligned with your needs, you’ll find valuable insights as you explore further.
Key Takeaways
- Sterile hydroponics prevent disease through microbe elimination, offering high control and predictability.
- Living hydro systems foster beneficial microbes that enhance nutrient uptake and plant resilience naturally.
- Choose sterile setups for high-value, sensitive crops needing consistent conditions; opt for living systems for sustainability.
- Sterile systems require more chemical inputs and maintenance; living systems rely on microbial balance and organic management.
- The decision depends on priorities: control and predictability versus ecological resilience and long-term sustainability.

Have you ever wondered whether sterile or living hydroponic systems are more effective for growing healthy plants? The choice between these two approaches can markedly impact your crop quality, growth rate, and overall system management. Sterile systems rely on thoroughly sanitized environments, free from any microbes, to prevent disease and pests. This means you start with clean nutrient solutions, sterilized equipment, and controlled conditions that minimize contamination risks. It offers a predictable environment where you can precisely control nutrient levels, pH, and moisture, making it easier to troubleshoot issues quickly. Many growers prefer sterile setups for high-value crops or in situations where disease outbreaks could be devastating, as they provide peace of mind that pathogens won’t take hold early on.
Sterile hydroponic systems offer predictability and disease prevention for high-value crops.
On the other hand, living hydroponic systems embrace the natural presence of beneficial microbes. These systems are designed to foster a thriving microbiome in your root zone, which can enhance nutrient uptake, improve plant resilience, and promote overall health. By introducing specific beneficial bacteria or fungi, you create a dynamic environment where plants and microbes coexist, often leading to stronger, more vigorous growth. Living systems tend to be more resilient against diseases because the beneficial microbes outcompete harmful pathogens, creating a natural biological barrier. They also tend to require less chemical intervention, aligning with organic and sustainable farming principles. Incorporating beneficial microbes can contribute to the robustness of your system and reduce the need for synthetic inputs. However, managing living systems demands a deeper understanding of microbial interactions and careful monitoring to maintain the delicate balance needed for ideal plant growth.
Choosing between sterile and living hydroponic systems depends on your goals, resources, and the crops you’re growing. If you’re aiming for consistency, quick troubleshooting, and minimal disease risk, sterile systems might suit you best. They’re especially useful if you’re new to hydroponics or grow sensitive plants that can be easily affected by pathogens. Conversely, if you’re interested in building a resilient, eco-friendly system that leverages natural biological processes, a living approach could be more rewarding. This method encourages microbial diversity, which can lead to healthier plants and potentially reduced input costs over time.
Ultimately, neither approach is inherently better—they are simply different strategies suited to different contexts. You need to assess your priorities: do you prefer control and predictability, or resilience and sustainability? Whichever route you choose, understanding the fundamental differences will help you make informed decisions to enhance your hydroponic success.

ZHANXUBIO Membrane Filter Sticker 58 mm 0.2 um Strong Adhersive Filter Disc for Mushroom Cultivation (58 mm,24 pcs)
Diameter :58 mm 0.2 um pore size ,PTFE membrane
As an affiliate, we earn on qualifying purchases.
As an affiliate, we earn on qualifying purchases.
Frequently Asked Questions
How Do Sterile and Living Hydro Systems Impact Plant Flavor?
Sterile hydro systems tend to produce cleaner, more neutral flavors since they prevent microbial activity that could alter taste. Living hydro systems, on the other hand, allow beneficial microbes to thrive, which can enhance flavor complexity and depth. If you prefer consistent, pure flavors, sterile setups are ideal. But if you’re looking for richer, more nuanced tastes, a living hydro system promotes natural microbial interactions that boost flavor profiles.
What Is the Environmental Footprint of Each Hydro Strategy?
You might be surprised, but each hydro strategy leaves a different mark on the environment. Sterile systems often use less water and energy since they prevent plant diseases, reducing waste. Meanwhile, living hydro promotes natural microbial balance, potentially lowering chemical inputs and runoff. Your choice impacts sustainability—sterile offers efficiency, while living emphasizes eco-friendliness. Consider your goals carefully; the environmental footprint goes beyond just water or energy use.
Can Sterile and Living Hydro Methods Be Combined Effectively?
Yes, you can combine sterile and living hydro methods effectively by integrating their strengths. Start with sterile techniques to minimize contamination, then introduce beneficial microbes gradually to boost growth and resilience. This approach allows you to control pathogens while promoting healthy microbial activity. By carefully managing conditions, you optimize yields, reduce risks, and create a balanced environment that leverages the advantages of both strategies seamlessly.
How Do Maintenance Requirements Differ Between Strategies?
Maintenance requirements differ markedly between strategies. With sterile hydro, you’re like a meticulous gardener, constantly sterilizing equipment and monitoring for contamination. It’s labor-intensive, needing regular cleaning and sterilization. Living hydro, on the other hand, is more like tending a natural garden—you focus on balancing nutrients and maintaining healthy microbial populations, which requires less constant sterilization but diligent monitoring. Both need attention, but sterile methods demand more hands-on upkeep.
Are There Specific Crops That Perform Better With One Approach?
Certain crops thrive better with either sterile or living hydro strategies. For example, leafy greens like lettuce and spinach often perform well with sterile systems because they require fewer microbial interactions. Conversely, herbs and fruiting plants such as tomatoes and peppers benefit from living hydro setups, which promote natural microbial activity to enhance growth and resilience. You should select the approach based on your crop’s specific needs and growth environment.

FoxFarm Bush Doctor Microbe Brew – Liquid Microbial Inoculant for Plants – Enhance Root Efficiency & Nutrient Uptake – Supports Hydroponic & Soil Applications for Flowers, Vegetables & Trees – 1 Pint
MAXIMIZE ROOT POTENTIAL:Microbe Brew is a liquid microbial inoculant that directly supports the root zone. It enhances root…
As an affiliate, we earn on qualifying purchases.
As an affiliate, we earn on qualifying purchases.
Conclusion
As you picture your hydro setup, think of sterile systems as a pristine, untouched pond—clean but empty, waiting to be filled with life. Living hydro, on the other hand, is like a bustling, vibrant river teeming with movement and energy, full of beneficial microbes. Choosing between them is like deciding whether to nurture a quiet lake or embrace a lively stream—each has its own beauty. Ultimately, your choice shapes the thriving ecosystem you cultivate.

Liquid Plant Food for use in AeroGarden, IDOO and Hydroponic Growing Systems, Liquid Fertilizer 8 oz (250mL)
Made for AeroGarden Systems – Formulated to support plant growth in AeroGarden and similar units.
As an affiliate, we earn on qualifying purchases.
As an affiliate, we earn on qualifying purchases.

Ahopegarden Indoor Garden Hydroponics Growing System: 10 Pods Plant Germination Kit Herb Vegetable Growth Lamp Countertop with LED Grow Light – Hydrophonic Planter Grower Harvest Lettuce
High planting efficiency: Start an indoor herb garden with the Ahopegarden hydroponic growing system, which includes a water…
As an affiliate, we earn on qualifying purchases.
As an affiliate, we earn on qualifying purchases.